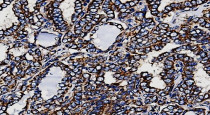
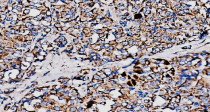

ARG43762
anti-Paxillin antibody
anti-Paxillin antibody for Flow cytometry,IHC-Formalin-fixed paraffin-embedded sections,Western blot and Human,Mouse,Rat
概述
| 产品描述 | Rabbit Polyclonal antibody recognizes Paxillin |
|---|---|
| 反应物种 | Hu, Ms, Rat |
| 应用 | FACS, IHC-P, WB |
| 宿主 | Rabbit |
| 克隆 | Polyclonal |
| 同位型 | IgG |
| 靶点名称 | Paxillin |
| 抗原物种 | Human |
| 抗原 | Recombinant protein corresponding to a.a. A9 - K570 of Human Paxillin. |
| 偶联标记 | Un-conjugated |
| 別名 | Paxillin |
应用说明
| 应用建议 |
|
||||||||
|---|---|---|---|---|---|---|---|---|---|
| 应用说明 | * The dilutions indicate recommended starting dilutions and the optimal dilutions or concentrations should be determined by the scientist. | ||||||||
| 实际分子量 | 60-66 kDa |
属性
| 形式 | Liquid |
|---|---|
| 纯化 | Affinity purification with immunogen. |
| 缓冲液 | 0.9% NaCl, 0.2% Na2HPO4 and 4% Trehalose |
| 稳定剂 | 4% Trehalose |
| 浓度 | 0.5 mg/ml |
| 存放说明 | For continuous use, store undiluted antibody at 2-8°C for up to a week. For long-term storage, aliquot and store at -20°C or below. Storage in frost free freezers is not recommended. Avoid repeated freeze/thaw cycles. Suggest spin the vial prior to opening. The antibody solution should be gently mixed before use. |
| 注意事项 | For laboratory research only, not for drug, diagnostic or other use. |
生物信息
| 数据库连接 | |
|---|---|
| 基因名称 | PXN |
| 全名 | paxillin |
| 背景介绍 | This gene encodes a cytoskeletal protein involved in actin-membrane attachment at sites of cell adhesion to the extracellular matrix (focal adhesion). Alternatively spliced transcript variants encoding different isoforms have been described for this gene. These isoforms exhibit different expression pattern, and have different biochemical, as well as physiological properties (PMID:9054445). [provided by RefSeq, Aug 2011] |
| 生物功能 | Cytoskeletal protein involved in actin-membrane attachment at sites of cell adhesion to the extracellular matrix (focal adhesion). [UniProt] |
| 预测分子量 | 61/65/66 kDa (Isoform alpha/beta/gamma) |
| 翻译后修饰 | Phosphorylated by MAPK1/ERK2 (By similarity). Phosphorylated on tyrosine residues during integrin-mediated cell adhesion, embryonic development, fibroblast transformation and following stimulation of cells by mitogens. Phosphorylation at Ser-244 by CDK5 reduces its interaction with PTK2/FAK1 in matrix-cell focal adhesions (MCFA) during oligodendrocytes (OLs) differentiation. Phosphorylation at Tyr-31 and Tyr-118 by PTK6 promote the activation of RAC1 via CRK/CrKII, thereby promoting migration and invasion. Phosphorylation at Ser-250 by SLK is required for PXN redistribution and cell motility (PubMed:23128389). [UniProt] |
检测图片 (5) Click the Picture to Zoom In
-
ARG43762 anti-Paxillin antibody IHC-P image
Immunohistochemistry: Paraffin embedded human hashimoto thyroiditis tissue stained withARG43762 anti-Paxillin antibody.
Antigen Retrieval: Heat mediation was performed in EDTA buffer (pH 8.0). -
ARG43762 anti-Paxillin antibody WB image
Western blot: HepG2 and mouse lung tissue stained with ARG43762 anti-Paxillin antibody.
-
ARG43762 anti-Paxillin antibody FACS image
Flow Cytometry: MCF-7 cells were fixed with 4% paraformaldehyde (10 min) and then permeabilized with 0.1% TritonX-100 for 15 min. The were stained with ARG43762 anti-Paxillin antibody.
-
ARG43762 anti-Paxillin antibody IHC-P image
Immunohistochemistry: Paraffin embedded hashimoto thyroiditis tissue stained withARG43762 anti-Paxillin antibody.
Antigen Retrieval: Heat mediation was performed in EDTA buffer (pH 8.0). -
ARG43762 anti-Paxillin antibody IHC-P image
Immunohistochemistry: Paraffin embedded human thyroid papillary carcinoma tissue stained withARG43762 anti-Paxillin antibody.
Antigen Retrieval: Heat mediation was performed in EDTA buffer (pH 8.0).